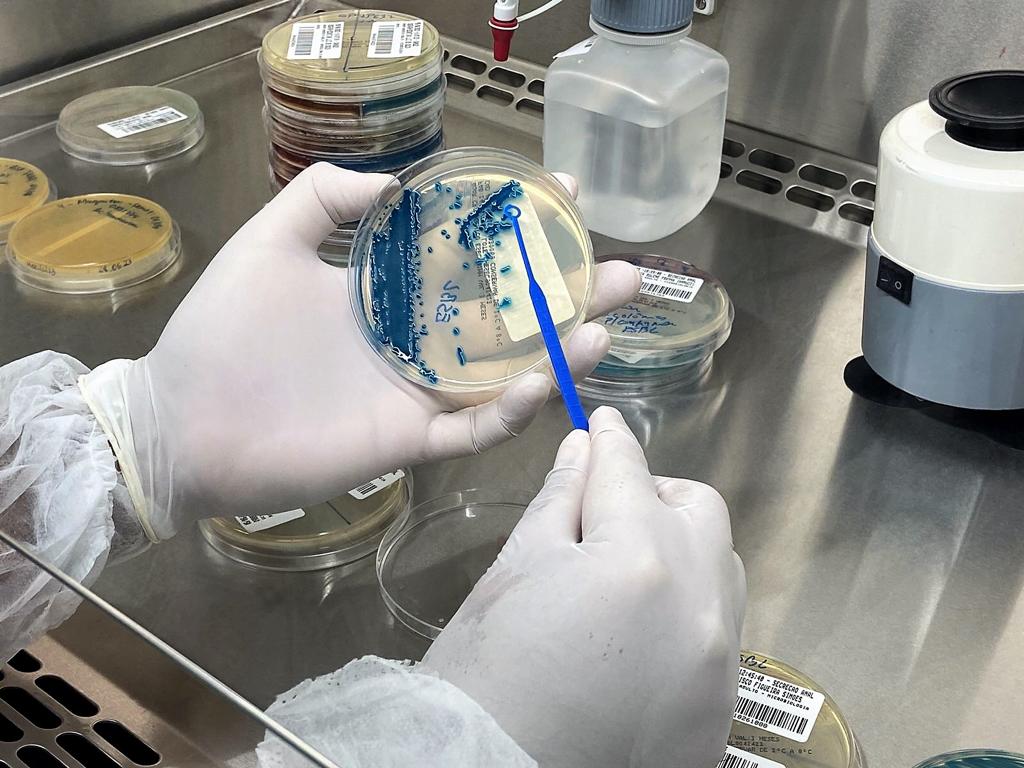

FVS-RCP e Hospital Delphina Aziz participam da iniciativa
O Amazonas é o único estado da Região Norte que participa da iniciativa BR Glass, um monitoramento sobre a resistência microbiana em serviços de saúde. A unidade participante é o Hospital e Pronto-Socorro Delphina Rinaldi Abdel Aziz. A ação é coordenada pela Fundação de Vigilância em Saúde Dra. Rosemary Costa Pinto (FVS-RCP), vinculada à Secretaria de Estado de Saúde (SES-AM).
O projeto de resistência antimicrobiana e sistema de vigilância de uso antimicrobiano (GLASS, na sigla em inglês), da Organização Mundial da Saúde (OMS), é resultado de uma parceria da SES-AM e FVS-RCP com Ministério da Saúde, Fundação Oswaldo Cruz (Fiocruz) e Laboratório Central de Saúde Pública do Paraná (Lacen-PR), além de ter o financiamento do Centro de Controle de Doenças e Prevenção (CDC), dos Estados Unidos.
Por meio da iniciativa, o Hospital e Pronto-Socorro Delphina Rinaldi Abdel Aziz recebem testes rápidos de detecção de resistência microbiana a tratamentos medicamentosos, utilizando tempo, diagnóstico e terapêutica adequada. Por parte do Governo Federal, o Ministério da Saúde envia insumos e apoio logístico para compor a iniciativa.
Veja também

Programa RespirAR realiza 1° Circuito de Apresentação de Casos Clínicos
O projeto inclui monitoramento anual por parte do CDC. Na unidade, a iniciativa ocorre desde agosto de 2022, podendo ser estendida até 2026. Além disso, o projeto compõe uma plataforma mundial de dados de microbiologia, com objetivo de ajudar na definição de ações para redução de risco de disseminação de microrganismos resistentes a tratamentos medicamentosos e infecções em serviços de saúde.
“As bactérias estão, cada vez mais, resistentes aos antibióticos. Esse projeto vai desde a melhoria do diagnóstico em hospitais até um conhecimento mais aprofundado das bactérias. É uma iniciativa que representa muito para o controle de infecções no Amazonas, porque essa é uma área da saúde extremamente importante e que buscamos intensificar ações em diversas frentes”, destaca Evelyn Campelo, coordenadora da Comissão Estadual de Controle de Infecção em Serviços de Saúde (Ceciss) da FVS-RCP.
O gerente do laboratório do Complexo Hospitalar Zona Norte (CHZN), que funciona dentro do Hospital Delphina Rinaldi Abdel Aziz, o farmacêutico bioquímico Rafael Brito, explica que, além dos exames que são processados pelo setor de microbiologia, são realizados alguns testes a mais na intenção de conseguir avaliar melhor o mecanismo de resistência dessas bactérias para que seja possível tratar de forma mais efetiva.
“Nós recebemos do Ministério da Saúde os kits de testes rápidos para detecção de carbapenemases, enzimas que tornam a bactéria resistente à maior parte dos antibióticos e avaliamos nossos pacientes, são testes com o objetivo de corroborar com o estudo em conhecer o perfil de resistência microbiana da nossa população, da nossa região amazônica, e conseguir tratar de forma assertiva”, pontua Rafael.
O BR Glass tem financiamento anual de cerca de US$ 800 mil (cerca de R$ 4,8 milhões) do CDC.
Monitoramento

Fotos: Divulgação
Por meio do BR Glass, as amostras de bactérias e fungos multirresistentes de pacientes coletadas e selecionadas nas unidades de saúde participantes, como o Hospital e Pronto-Socorro Delphina Rinaldi Abdel Aziz, são enviadas aos Laboratórios Centrais de Saúde Pública (Lacen). Em Manaus, as amostras serão encaminhadas para o Lacen-AM, integrante da FVS-RCP.
Curtiu? Siga o Portal Mulher Amazônica no Facebook, Twitter e no Instagram.
O fluxo de encaminhamento de amostra segue ao Laboratório de Pesquisa em Infecção Hospitalar do Instituto Oswaldo Cruz (LAPIH/IOC/Fiocruz) e ao Lacen-PR. Os dados, das unidades participantes da iniciativa, são lançados no sistema de monitoramento do BR-GLASS para que seja realizado acompanhamento em tempo real.
Fonte: com informações da Assessoria de Comunicação da Fundação de Vigilância em Saúde do Amazonas
Copyright © 2021-2026. Mulher Amazônica - Todos os direitos reservados.